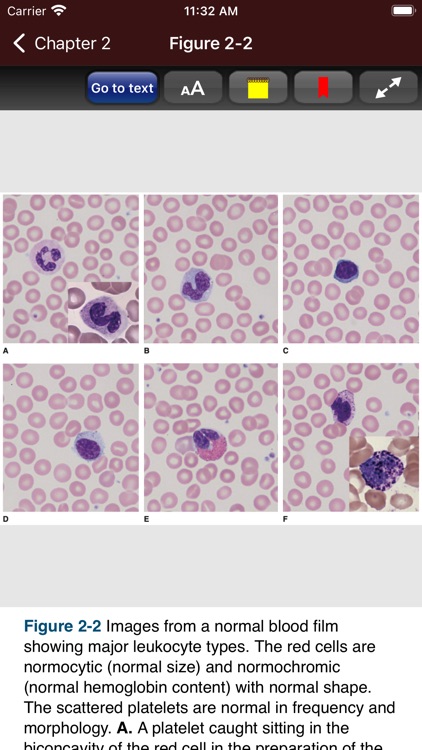
Williams Hematology, 10E screenshot-6

The landmark text that has guided generations of hematologists and related practitioners-updated with the latest research findings and improved format and presentation
Williams Hematology, 10E



What is it about?
The landmark text that has guided generations of hematologists and related practitioners-updated with the latest research findings and improved format and presentation.

App Screenshots

App Store Description
The landmark text that has guided generations of hematologists and related practitioners-updated with the latest research findings and improved format and presentation.
Doody's Core Titles for 2021!
Long revered for its comprehensiveness and extraordinary depth of detail, Williams Hematology provides essential coverage of the origins, pathophysiological mechanisms, and management of benign and malignant disorders of blood and marrow cells and coagulation proteins. The text contains a wealth of basic science and translational pathophysiology for optimal, lifelong learning. Experts in research and clinical hematology, the editors are known worldwide for their contributions to the field.
This new edition contains everything that has made Williams Hematology the go-to resource for decades and has been updated with new chapters and critical new research into the molecular mechanisms responsible for hematological disorders and the impact on diagnosis and treatment. And the new format enables you to access each chapter via content modules covering key topics, with summaries, infographics, and cases?all linked to review questions for self-assessment. The full-color presentation integrates images of blood and tissue findings where they are cited in the text.
NEW TO THIS EDITION:
• Updated and revised content reflecting the latest research and developments
• Convenient format that streamlines the learning process and improves retention
• Williams Hematology Cases including detailed explanations—perfect preparation for the boards
• Continuously updated online content with comprehensive drug therapy database and other resources
• Additional chapters added on:
-Immune Checkpoint Inhibitors
-Immune Cell Therapy: Chimeric Antigen Receptor T Cell Therapy
-Immune Cell Therapy Dendritic Cell and Natural Killer Cell Therapy
-The processes of cell death and survival
-Application of Big Data and Deep Learning in Hematology
This app is very intuitive and easy to navigate, allowing you to browse the contents or search for topics. The powerful search tool gives you word suggestions that appear in the text as you type, so it is lightning fast and helps with spelling those long medical terms. The search tool also keeps a recent history of past search terms so you can go back to a previous search result very easily. You have the ability to create notes and bookmarks separately for text, images and tables to enhance your learning. You can also change the text size for easier reading.
After the app has been downloaded, no internet connection is needed to retrieve the content of the app. All of the text and images are available to you on your device anytime, anywhere, and lightning fast. This app is also automatically optimized for whatever size device you are currently using, either phone or tablet.
This interactive app contains the full content of Williams Hematology, 10th Edition by McGraw-Hill Education.
ISBN-13: 978-1260464122
ISBN-10: 1260464121
Editors:
Kenneth Kaushansky, MD, MACP
Marshall A. Lichtman, MD, MACP
Josef T. Prchal, MD
Marcel Levi, MD, PhD, FRCP
Linda J. Burns, MD
David C. Linch, FRCP, FRCPath, FMed Sci
Disclaimer: This app is intended for the education of healthcare professionals and not as a diagnostic and treatment reference for the general population.
Developed by Usatine Media
Richard P. Usatine, MD, Co-President, Professor of Family & Community Medicine, Professor of Dermatology and Cutaneous Surgery, University of Texas Health San Antonio
Peter Erickson, Co-President, Lead Software Developer
AppAdvice does not own this application and only provides images and links contained in the iTunes Search API, to help our users find the best apps to download. If you are the developer of this app and would like your information removed, please send a request to takedown@appadvice.com and your information will be removed.